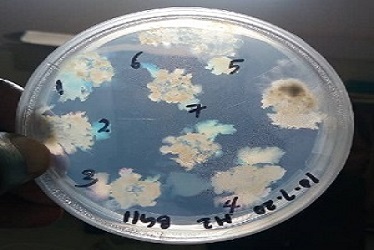
card1

To reduce industrial pollution into Lake Victoria
To enhance utilization of microalgae in industrial effluent management in Uganda
To determine algae bloom species composition in Lake Victoria and its basin.

Investigating the environmental condition of Algal bloom waters at Murchison Bay.
Last updated in 2020

Algal bloom floating on Lake Victoria waters
Last updated in 2020
Algal bloom database for lake victoria and its basin
Table of the different species
| Location | Species | Cell per ml (av.) Years (2018/2019 |
Lake Victoria | Microcystis aeruginosa | 39051 |
|---|---|---|
| Lake Victoria | Merismopedia tenuissima | 8324 |
| Lake Victoria | Dolichospermum circinale | 2430 |
| Waste Water | Spirulina platensis | 2618 |
To determine the efficacy of different algae species in effluent management.

Harvesting algae at Kirinya waste water treatment ponds.
Last updated in 2020

Algae grown at small scale to test their efficiency in removal of pollutants (nutrients) from industrial effluent
Last updated in 2020

Testing Algae efficiency in removal of pollutants from industrial effluent at large scales.
Last updated in 2020
To determine ways of disposing of the excess algae

Harvested Algae from the experiments..
Last updated in 2020
Microalgae on solid nutrient media during isolation for growing pure strains
Last updated in 2020
Progress to be reported during cultural experiments.
To determine socio-economic losses associated with the algal bloom

Reparian catchment deforestation. (for firewood).
Last updated in 2020

Researchers collecting data on the causes and effects of algal blooms.
Last updated in 2020

Worms under the algal bloom affects the skin of the fishers.
Last updated in 2020
Qualitative study undertaken at determine the socio-economic losses.
click to view focus group discussion summary
| Group | Species | Average cells per ml |
|---|---|---|
| Years (2018/2019) | ||
| Cyanobacteria | Microcystis aeruginosa | 39051 |
| Cyanobacteria | Merismopedia tenuissima | 8324 |
| Cyanobacteria | Dolichospermum circinale | 2430 |
| Cyanobacteria | Arthrospira platensis | 2618 |